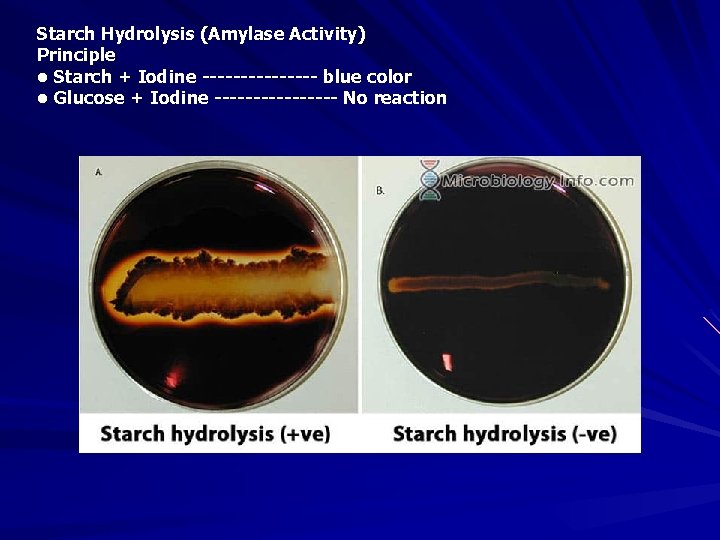
Starch Hydrolysis (Amylase Activity) Principle • Starch + Iodine -------- blue color • Glucose

Grampositive bacilli Aerobic Facultative anaerobic Non spore forming

. Gram-positive bacilli Aerobic Facultative anaerobic Non spore forming Listeria Erysipelothrix Actinobacteria Bacillus Anaerobic Spore forming Clostridium

General Characteristics of the Genus Bacillus Gram-positive, endospore-forming, motile rods Aerobic and catalase positive Source of antibiotics Primary habitat is soil 2 species of medical importance: – Bacillus anthracis – Bacillus cereus


Anthrax Biological Terrorism ØMalignant Pustule ØMalignant Edema ØWool sorters disease ØSpleenic Fever

Characteristics n n n Bacillus anthracis Large, Gram positive, non-motile rod Vegetative form & spores Nearly worldwide distribution Over 1, 200 strains

Culture n Non-motile, spore-forming bacilli with square ends n “Medusa-head” colonies are like thick, wavy hairs under low power objective. Effect of CO 2 Dry leathery irregular colonies, close-up show wavy replicating rows of cells - Medusa head colonies

The Sporulation requires – Poor nutrient conditions – Presence of oxygen Spores – Very resistant to extremes – Survive for decades – Taken up by host and germinate Lethal dose 2, 500 to 55, 000 spores
Starch Hydrolysis (Amylase Activity) Principle • Starch + Iodine -------- blue color • Glucose + Iodine -------- No reaction

Virulence factors : - B. anthracis contains 2 plasmid encoded virulence factors: Capsule ---- linear γ- D- glutamic acid polymer. b) Exotoxin (Trimer

Animal Transmission Most commonly infected by ingestion from contaminated soil or contaminated feed or bone meal

Clinical Signs in Animals Signs differ by species – Ruminants at greatest risk Three forms of illness – Peracute Ruminants (cattle, sheep, goats, antelope) – Acute Ruminants and equine – Subacute-chronic Swine, dogs, cats

Peracute infection – Rapid onset – Sudden death – Bloody discharge from body orifices – Incomplete rigor mortis – Rapidly bloat n Chronic infection Pharyngeal and lingual edema n Ventral edema n Death from asphyxiation n n Treatment successful if started early

Diagnosis and Treatment Necropsy not advised! Do not open carcass! Samples of peripheral blood needed – Cover collection site with disinfectant soaked bandage to prevent leakag 4 - laboratory 3 - animal inoculation 4 - Elisa

Direct smear Mc. Fadyean’s reaction Pink coloration seen around cells

Ascolis test

Anthrax: Control Vaccination – Successful in endemic areas – Stern’s spore vaccine Contains a strain of B. anthracis without a capsule (cured of p. XO 2 plasmid) Organism is cleared rapidly from circulation Protective antibodies are induced

Anthrax: Treatment Effective treatment in the face of an outbreak includes: Intravenous crystalline – penicillin Antiserum –

Human Transmission Industry Tanneries – Textile mills – Wool sorters – Bone processors – Slaughterhouses –

Cutaneous – Contact with infected tissues, wool, hide, soil – Biting flies Inhalational – Tanning hides, processing wool or bone Gastrointestinal – Undercooked meat

Zoonotic Potential Woolsorter’s Disease – Fulminant respiratory infection – Common in imported raw hide and wool (sorters) Malignant carbuncle – Cutaneous form of B. anthracis

Human Disease: Forms Cutaneous form: Skin form (Pathologists / Veterinarians)

Ingestional form or GI form (eating affected animals)

Inhalational or Pneumonic form Bioterrorism/ Wool Sorters Disease EM: Blood vessel with anthrax Lung Blood capillary plugged With Bacillus anthracis

Diagnosis in Humans Isolation of B. anthracis – Blood, skin – Respiratory secretions Serology ELISA Nasal swabs – Screening tool

Anthrax quick ELISA test – New test approved by FDA on June 7 th, 2004. – Detects antibodies produced during infection with Bacillus anthracis – Quicker and easier to interpret than previous antibody testing methods Results in less than ONE hour

Treatment Penicillin – Has been the drug of choice – Some strains resistant to penicillin and doxycycline Ciprofloxacin – Chosen as treatment of choice in 2001 – No strains known to be resistant Doxycycline may be preferable
- Slides: 26